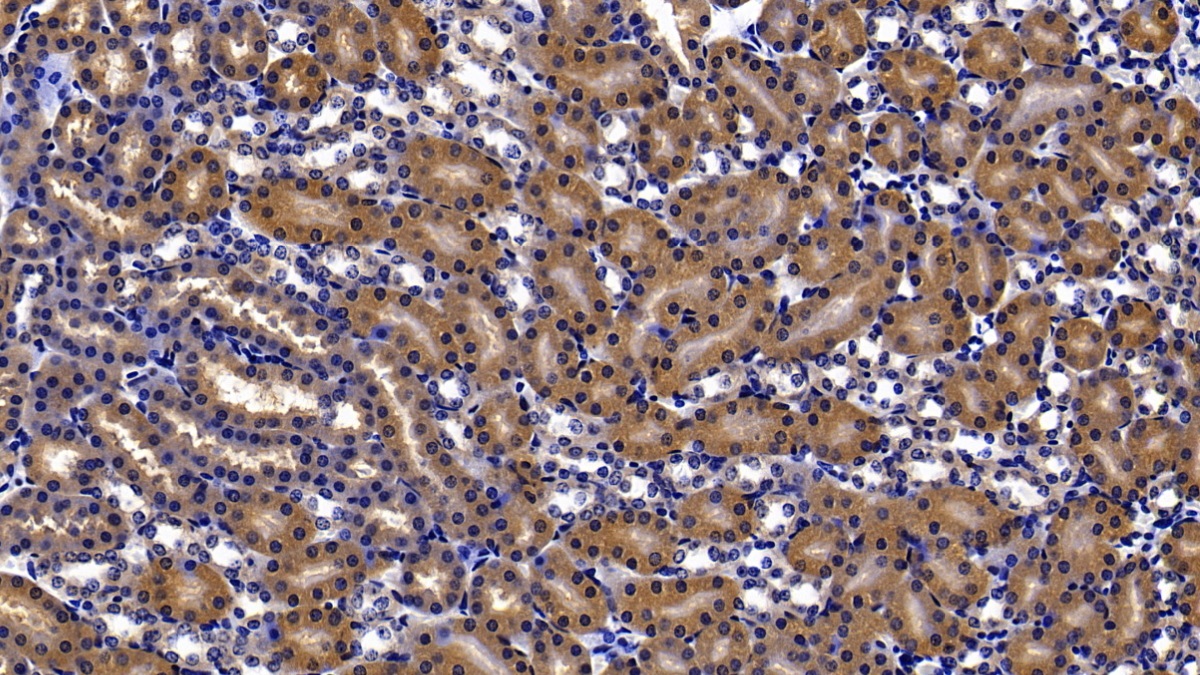
26840

| Русское название |
PAA703Mu01 Поликлональное антитело к TXNRD1 (мышь) <Cloud-Clone,Китай> |
| Каталожный номер |
PAA703Mu01 |
| Название антигена |
Thioredoxin Reductase 1 (TrxR1) |
| UNIPROT |
Q9JMH6 |
| Иммуноген |
RPA703Mu01-Recombinant Thioredoxin Reductase 1 (TXNRD1) |
| Английские синонимы |
TXNRD1, TR1, GRIM12, KDRF, TRXR-1, TXNR, Gene associated with retinoic and interferon-induced mortality 12 protein, KM-102-derived reductase-like factor |
Реактивность подтвержденная Нужна другая реактивность? |
мышь |
| Реактивность предсказываемая |
человек |
| Источник (хозяин) |
кролик |
| Клональность |
поликлональное |
| Рекомбинантное |
нет |
| Готовое к использованию |
нет |
| Концентрация |
0.37 мг/мл |
| Конъюгат |
По запросу: HRP, biotin, PerCP, PE, Cy3, FITC, Cy7, Cy5.5, PE-Cy5, PE-Cy7, PerCp-Cy5.5, APC, Cy5, PE-Cy3, PE-Cy5.5, APC-Cy7, Biotin-APC, FITC-Biotin, TRITC, APC-Cy5, AF488, AF594, AF405, AF555, AF700, AF647, AF750 |
| Валидировано для |
Иммуногистохимия; Вестерн-блоттинг |
| Рекомендуемые разведения |
WB: 0.5-5 мкг/мл; IHC: 5-50 мкг/мл; ICC: 5-50 мкг/мл; Оптимальное разведение определяется конечным потребителем |
| Метод очистки |
Антигенспецифическая аффинная хроматография с последующей аффинной хроматографией с белком А |
| Состав буфера |
PBS, pH7.4, 0.02% NaN3, 50% глицерин |
| Условия доставки |
термобокс с аккумуляторами холода |
| Условия хранения |
Сразу после получения аликвотировать и хранить при -20ºС до 24 месяцев. Для частого использования хранить при +4ºС не более 2 недель. Избегать повторения циклов замерзания/оттаивания |
| Срок хранения |
24 месяца |
| Производитель |
Cloud-Clone Corp. |
| Ссылка на страницу товара на сайте производителя |
http://www.cloud-clone.com/products/PAA703Mu01.html |